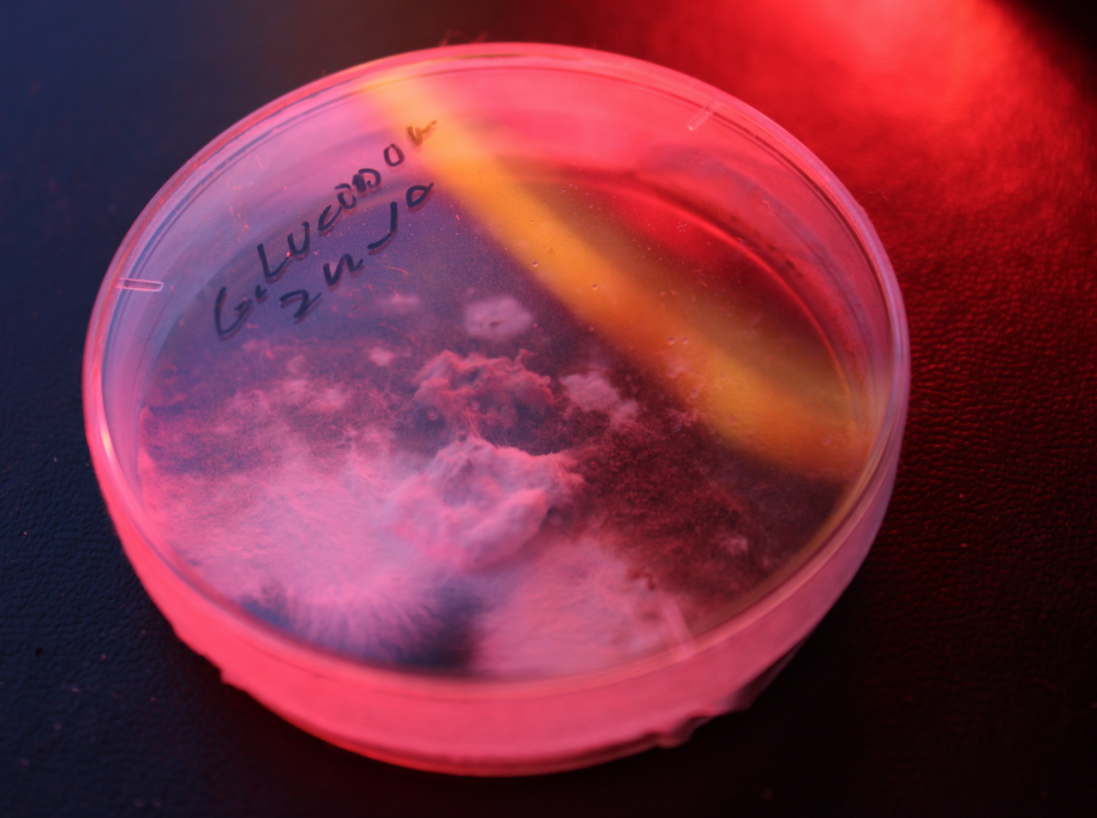

April 7, 2025, from 1 PM
Technological Center UMPRUM, Mikulandská 5, Prague 1, 3rd floor, cinema
The K.O.V. studio is pleased to invite you to a lecture where performative artist and designer Ines Borovac and artist Rebecca Schedler will present their work.
The lecture will be held in English.
Ines Borovac is a performance artist and designer based in Rotterdam, NL. She holds a master’s degree from Design Academy Eindhoven where she developed her practice of performative design. As a feminist, in her practice, Borovac infiltrates various systems regulated by normative values (e.g. traditions, religious rituals, workspaces...) with the aim of exploring future gestures and giving immediacy to the oppressed. Her pieces are activated by the performances and often penetrated by the contingent bodies. As a female Balkan woman, she deals with the deconstruction of Balkan folk traditions whilst twisting the power dynamics of patriarchal influence. Since 2022 together with Ginevra Petrozzi, Borovac has been working as a co-founder of the art and design duo Xsenofemme. Her work was exhibited at Ars Electronica, MU hybrid house, Museum of contemporary art Zagreb among others.
inesborovac.com
Rebecca Schedler is a designer and researcher from Germany. She investigates complex relations between social, cultural, political, and environmental issues by exploring the intersection of design and science. Her work deals with interspecies interactions, technology, taken-for-granted materials, such as mushrooms and shit, and how these could lead to a more shared and equal future. Through a Bioreactor-system, she explores hidden systems, the unseen and the abject, which form a vital part of our environment and living space with their life, age, and death. Rebecca graduated from the Design Academy Eindhoven (NL) with a Master‘s in Social Design and holds a Bachelor‘s degree in Textile- and Surface Design from the Kunsthochschule Weißensee Berlin (DE). She is currently active as a tutor for the Master Class “Social Landscapes and Materials” at DAE.
rebecca-schedler.com